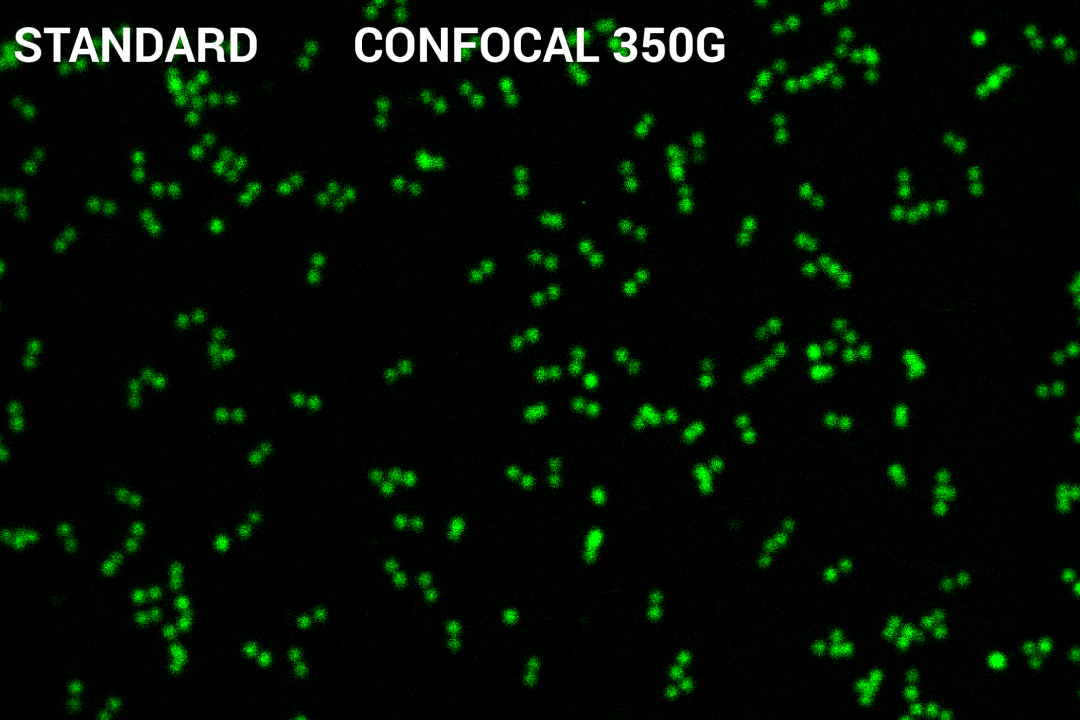
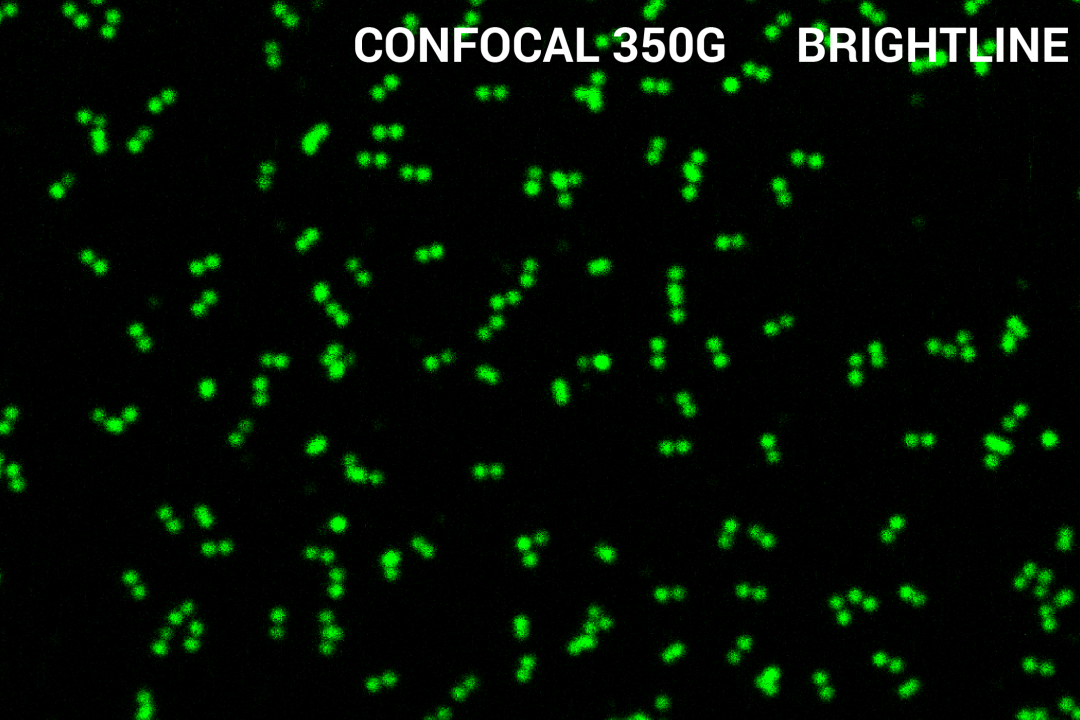

Nanorulers from the GATTA-Confocal series are designed for users of classical (i.e. diffraction limited) microscopy systems. The rulers carry two fluorescent marks out of multiple high quantum yield dye molecules. Thereby the mark-to-mark distance has a value of 350 nm. GATTA-Confocal rulers are available in the colors red (ATTO 647N), yellow (Alexa568), green (ATTO 532) or blue (Alexa488).
On request we can also design special solutions for your specific requirements. All samples will be delivered on a sealed glass slide which you can comfortably put directly on your microscope.
 GATTA-Confocal - brightline
 GATTA-Confocal - brightlineCurrently we provide as colors red (ATTO 647N), yellow (ATTO 565), green (ATTO 543) and blue (Alexa Fluor 488).

GATTA-Confocal - brightline series
 GATTA-Confocal - brightline series| Nanoruler | Confocal 350R - brightline | Confocal 350Y - brightline | Confocal 350G - brightline | Confocal 350B - brightline | 
|---|---|---|---|---|
| Color | red | yellow | green | blue | 
| Fluorophore | ATTO 647N | ATTO 565 | ATTO 532 | Alexa Fluor® 488 | 
| Recommended laser source | 630 - 650 nm | 540 - 585 nm | 515 - 540 nm | 480 - 505 nm | 
| Surface density | ≈ 1/μm² | ≈ 1/μm² | ≈ 1/μm² | ≈ 1/μm² | 
| Distance | 350 nm | 350 nm | 350 nm | 350 nm | 
| Level | Beginner | Beginner | Beginner | Beginner | 
| Price | 350,-€ | 350,-€ | 350,-€ | 350,-€ | 
| Nanoruler | GATTA-Confocal RYB - brightline* | GATTA-Confocal RGB - brightline* | 
|---|---|---|
| Color | red / yellow / blue | red / green / blue | 
| Fluorophore | ATTO 647N / ATTO 565 / Alexa Fluor® 488 | ATTO 647N / ATTO 532 / Alexa Fluor® 488 | 
| Recommended laser source | 630 - 650 nm / 540 - 585 nm / 480 - 505 nm | 630 - 650 nm / 515 - 540 nm / 480 - 505 nm | 
| Surface density | ≈ 1/μm² | ≈ 1/μm² | 
| Distance | red: 350 nm / yellow: 320 nm / blue: 270 nm | red: 350 nm / green: 290 nm / blue: 270 nm | 
| Level | Beginner | Beginner | 
| Price | 400,-€ | 400,-€ | 
*All confocal multiruler distances can of course be ordered seperately! If you should wish a quotation for one these distances please inform us in the field "note".
The standard version of our GATTA-Confocal nanorulers you can still request on our legacy products page.
Beginner: Samples to check the basic functions of your microscope. Easy to resolve, also for beginners in the field of microscopy.
| Fluorophore | Our notation | Excitation / nm | Emission / nm | 
| ATTO 647N | R | 647 | 664 | 
| ATTO 565 | Y | 564 | 590 | 
| ATTO 532 | G | 532 | 552 | 
| Alexa Fluor 488 | B | 488 | 525 | 
 Full size super-resolution Image of GATTA-Confocal 350B
Full size super-resolution Image of GATTA-Confocal 350B
 Full size super-resolution Image of GATTA-Confocal 320Y
Full size super-resolution Image of GATTA-Confocal 320Y
 Full size super-resolution Image of GATTA-Confocal 270B
Full size super-resolution Image of GATTA-Confocal 270B
Image Courtesy: Christian Jüngst, CECAD Imaging Facility (brightline comparison)
 
        